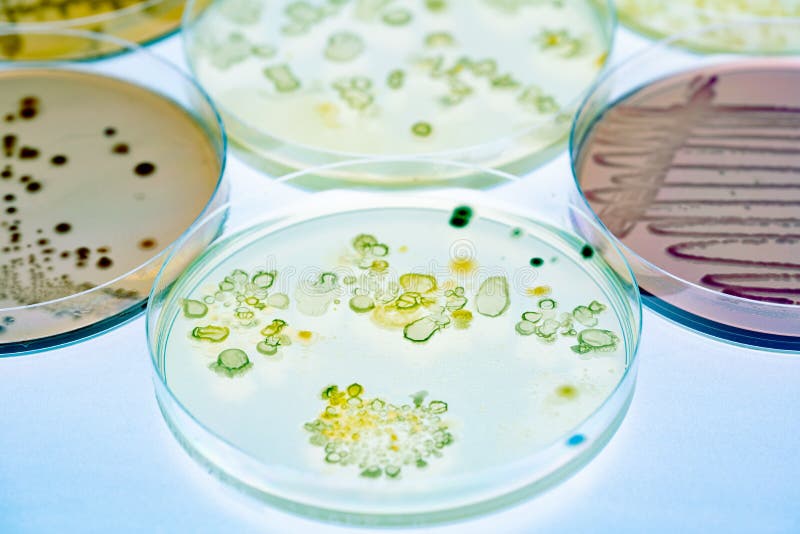

Виды колоний актиномицетов на разных питательных средах


































































.JPG)

/PLF-Pyothorax-GST-Feline-63x.jpg)

































Раздел: Другие животные